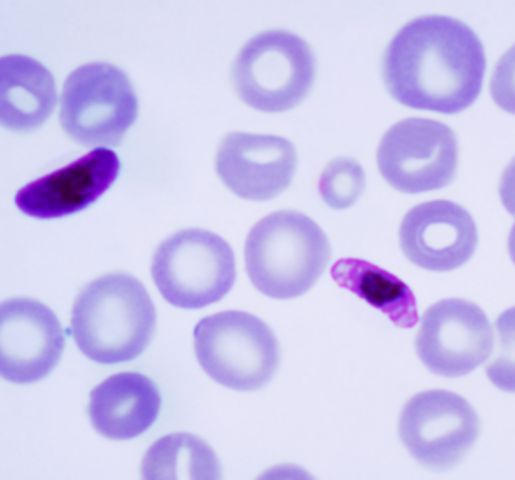
TP Nº: Paludismo
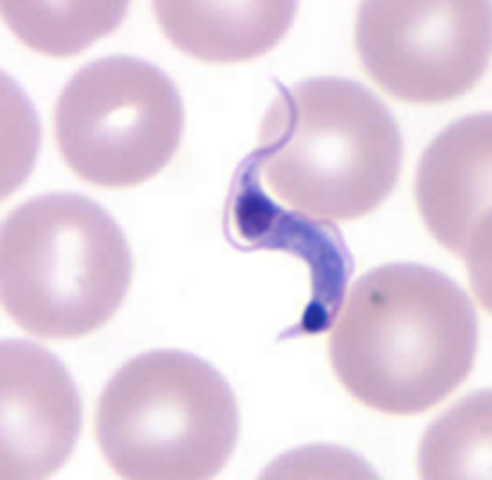
TP Nº 13: Hemoflagelados: Tripanosomas

-
-
Conceptos y definiciones
-
Tipos de muestras.
-
Metodos Directos e Indirectos en la investigación y el diagnóstico de parásitos
-
Observación microscópica de artefactos.
-
Entamoeba hystolítica
Ameba dispar
Entamoeba hartmanni
Entamoeba coli
Iodamoeba butschilli
Endolimaz nana -
Giardia lamblia
Chilomastix mesnilli
Trichomona vaginalis
Balantidium coli
Cystoisospora belli
Criptosporidium spp -
Taenia solium
Taenia saginata
Diphylidium caninum
Diphyllobotrium latum
Hyminolepis nana
Hyminolepis diminuta -
Fasciola hepática
Schistosoma spp -
Áscaris lumbricoides
Enterobius vermicularis
Trichuris trichiura
Uncinarias spp
Strongiloides stercoralis -
-
Sarcocystis sp
-
Toxoplasma gondii
-
Plasmodium spp
-
Tripanosoma cruzi
-
Leishmania
-
Echinococcus granulosus
Taenia solium -
Trichinella spiralis
Toxocara spp
Filarias spp -
Parasitosis que afectan a los pacientes con inmunodepresión.
-
-
A list shows items. A timeline shows sequence.
Use Timetoast to make dates, milestones, and turning points easier to understand in a clear visual format. Timetoast is a timeline maker for work, school, research, and stories.